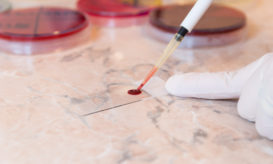

Η ακτινοβολία από τις αξονικές τομογραφίες συνδέεται με αυξημένο κίνδυνο καρκίνου
Νέα έρευνα που δημοσιεύτηκε στην επιστημονική επιθεώρηση "JNCL Cancer Spectrum" διαπίστωσε ότι η έκθεση σε ακτινοβολία από αξονικές τομογραφίες...

Νέα έρευνα που δημοσιεύτηκε στην επιστημονική επιθεώρηση "JNCL Cancer Spectrum" διαπίστωσε ότι η έκθεση σε ακτινοβολία από αξονικές τομογραφίες...

Σε αυτό το άρθρο, εξετάζουμε διεξοδικά τις ομοιότητες και τις διαφορές μεταξύ της λευχαιμίας και του λεμφώματος.

Το σώμα ενόρκων δικαστηρίου του Σαν Φρανσίσκο επέβαλε στην Bayer να καταβάλει πάνω από 80 εκατομμύρια δολάρια σε έναν...

Δικαστήριο έκρινε ότι ένα ζιζανιοκτόνο της εταιρείας Bayer AG με βάση τη γλυφοσάτη υπήρξε "ουσιαστικός παράγοντας" στην εμφάνιση καρκίνου...

Ελπίδες για μακρά και καλής ποιότητας ζωής προσφέρουν οι νέες θεραπείες σε ασθενείς με λέμφωμα που είτε είναι εξ...
Η πιο συχνή μορφή καρκίνου στο αίμα είναι το λέμφωμα, ενώ δεύτερη σε συχνότητα είναι η λευχαιμία. Ωστόσο και...

Η λευχαιμία και το λέμφωμα έχουν διάφορα συμπτώματα, που όμως είναι μη ειδικά, δηλαδή μπορεί να οφείλονται και σε...

Το Λέμφωμα είναι ένας καρκίνος του ανοσοποιητικού συστήματος. Υπάρχουν πολλοί τύποι λεμφώματος

Το λέμφωμα είναι ο καρκίνος ενός τμήματος του ανοσοποιητικού συστήματος, του λεμφικού συστήματος. Υπάρχουν πολλοί τύποι λεμφώματος. Ένας από...